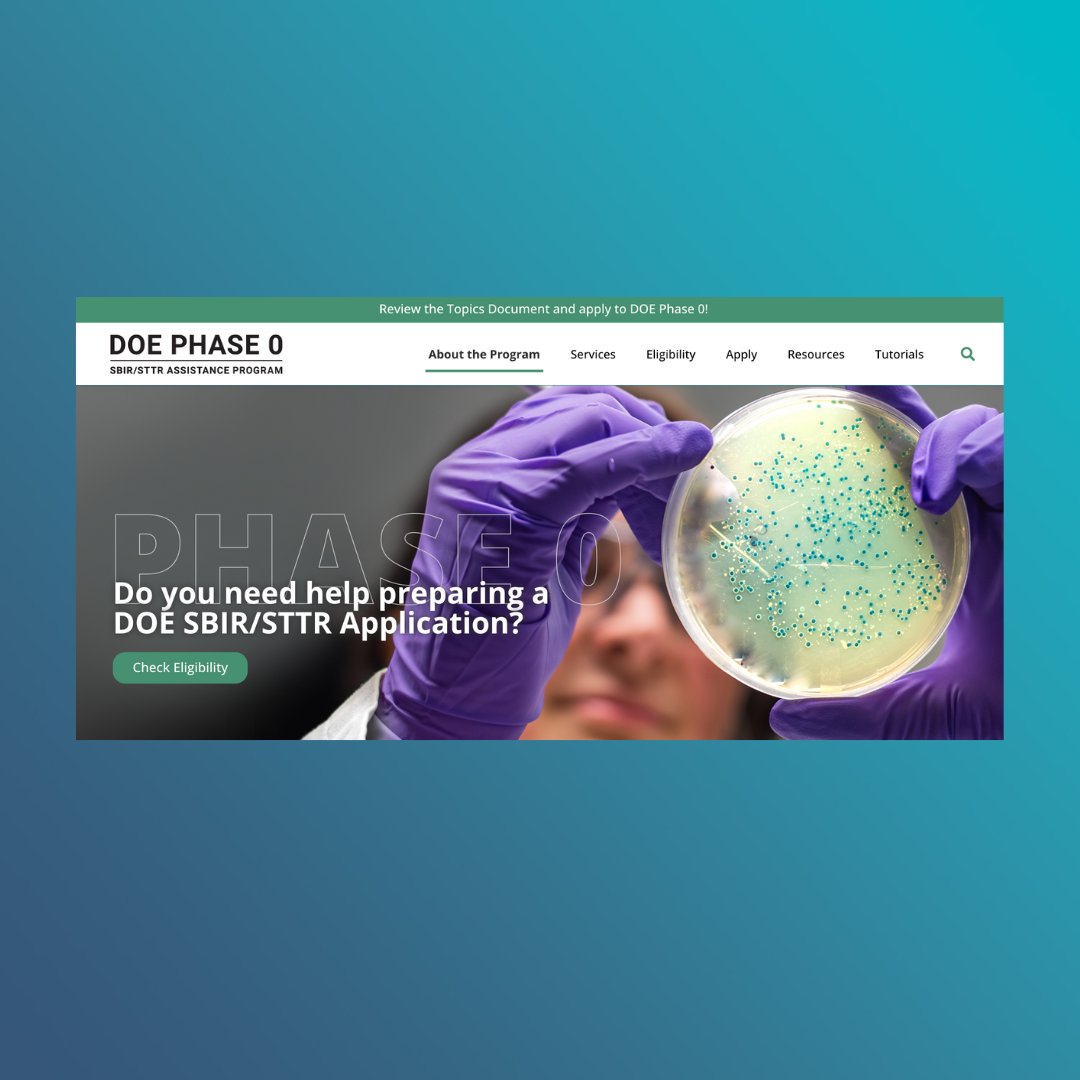
🚨 Great opportunity for tech entrepreneurs and small tech companies 🚨

The Department of Energy is seeking technology entrepreneurs with expertise in renewable energy and beyond. Letters of intent are due on January 3, 2023. Learn more ➡️ doephase0.dawnbreaker.com

WeBuildGreenCities
@pdxgreencities
We Build Green Cities aim is to better connect Portland's green innovations, intellectual capital and products with the rest of the world. #WBGCpdx
ID: 394972954
http://www.webuildgreencities.com 20-10-2011 22:41:34
1,1K Tweet
831 Followers
855 Following



Portland-based Daimler Truck NA to deliver 92 Freightliner eCascadia trucks to $SNDR, helping the trucking company to grow into one of the country's largest EV fleets. bizjournals.com/portland/news/…



#Portland again becomes the first in the nation to take bold #climateaction and will phase out petroleum diesel by 2030 to be replaced by renewable and biodiesel. Kudos to Portland Bureau of Planning and Sustainability & Commissioner Carmen Rubio office for their hard work. oregonlive.com/news/2022/12/p…




Still struggling to understand everything in the #InflationReductionAct ? The The White House released a detailed guidebook on it to help you navigate as we await more details in 2023. whitehouse.gov/cleanenergy/in…






Congrats Pitch Oregon Finalists in the Clean Tech Category - Bold Reuse Ren Energy & Pure Blue Tech -Attend February 9th - oregon.tie.org/pitch-oregon-2…




Excited to attend #NOWCon23 tomorrow to do a deep dive on the future of #floatingoffshorewind in #Oregon. Prosper Portland is a proud sponsor.

. University of Oregon and the University of Oregon Foundation have jointly established Launch Oregon, LLC to assist University of Oregon researchers on the journey from eureka moment to successful business. research.uoregon.edu/launch-oregon